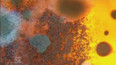
EU proti nadužívání antibiotik

28. listopadu 2009
Obsah dílu
EU proti nadužívání antibiotik — Záchrana krokodýlů v Kambodži — Terapie nedošených dětí — Teleskop v Chile — Rybáři z Ugandy
Části dílu

Přehled dílů

30. června 2012
Krajta tmavá v národním parku Everglades — Levhart jávský na Jávě — Viry a věda — Speciální kompresní oblek pro koně — Genová terapie — Termité jako vzor pro roboty — Malovací program Painting Fool

23. června 2012
Ekologická nafta — Recyklace — Umělé hlasivky — Nová družice NuSTAR — Prsní implantáty PIP — Seismologie — Jak zlevnit výrobu skla — Virtuální město

16. června 2012
Mikročip místo orgánů — Biodynamické zemědělství — Brýle na celý život — Jak odolný je komár — Nejmenší nadzvukové letadlo — Problém vozíčkářů ve městech — Wikiměsto — Divocí koně — Anténa ve tvaru cedru

9. června 2012
Britští přírodovědci přepisují paleontologii — Kouzla s kmenovými buňkami — Špionážní mise Korejců — Potkani s poraněnou míchou — Vodní filtr — Hudební nástroj pro neposedné prsty

2. června 2012
Jak změní úraz mozku chování člověka — Závod ekologických aut — Ledovce tají rychleji, než se čekalo — Mikroroboti — Sofistikovaný dojicí automat — Zahrada pro alergiky — Pritzkerova cena — Bezpilotní letadlo hlídá pytláky v Indonésii

26. května 2012
Léčba kmenovými buňkami — Káva je zdravá — Osobní vozítko — Hmotu lze kontrolovat myšlenkami — Klíč k předcházení demenci — Padělané léky proti malárii — Choroby srdce u primátů — Eko-vesnice podle Tolkiena — Běhat v botách, nebo naboso?

19. května 2012
Psi hlídají ohrožené gorily — Veletrh speciálních jednotek — Videorozhodčí ve fotbale — Voda ve světových oceánech se mění — Magnet odpuzuje žraloky — Kari proti rakovině — Římský akvadukt v ohrožení — Ekologická zoo — Generátor na lidský pohon

12. května 2012
Domy ze slámy — Fotoakustická tomografie — Řidičská akademie v USA — Kloubní implantáty — Varující látka poraněných ryb — Australští tučňáci — Stavební boom v Thajsku — Bionické oko

5. května 2012
Program na sledování plavců — Orangutani používají tablet — DNA popis rostlin — Nový mechanický exoskeleton — Detailní záběry anatomie vodního brouka — Bilingvnost a mozek — Ovce křížená se škrkavkou — Hon za majoránou — Robot chodí do školy

28. dubna 2012
Zrakové ovládání počítačů — Syndrom bílého nosu — Chytrý jako pavián — Transplantace vlasů — Brýlemi proti poruše příjmu potravy — Unikátní simulace zemětřesení — Medvěd hnědý se vrací do přírody — Cyklista Eric Barone



